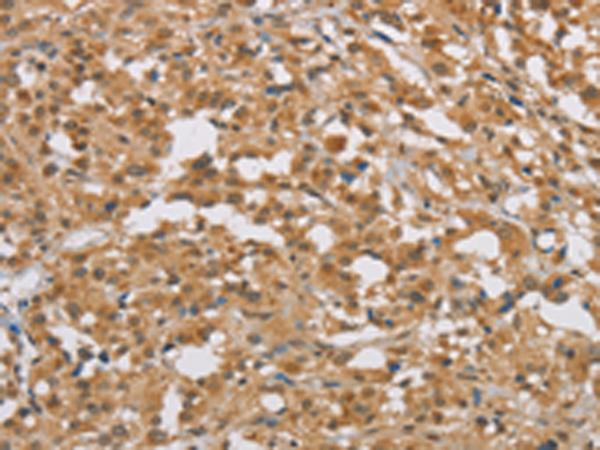
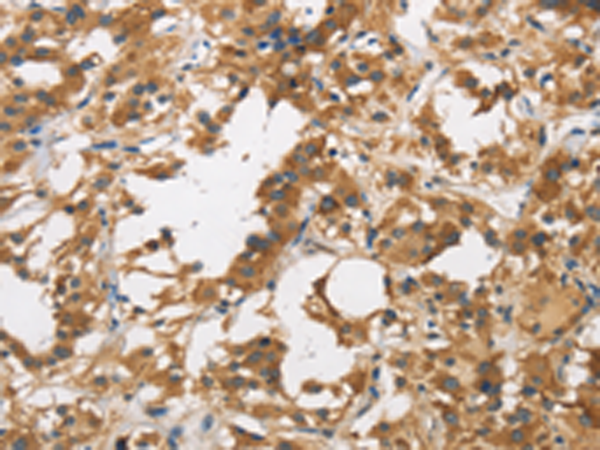

-
分类: 科研抗体货号: P08217别名: DBM应用: WB,IHC反应种属: Human, Mouse
-
分类: 科研抗体货号: P08216别名: DBC1; FAM5A; DBCCR1应用: IHC反应种属: Human, Mouse, Rat
-
分类: 科研抗体货号: P08236别名: HDGC; CDHF5; ARVC10; ARVD10; CMD1BB应用: IHC反应种属: Human
-
分类: 科研抗体货号: P08215别名: BYE1; DIO1; DATF1; DIDO2; DIDO3; DIO-1; DATF-1; C20orf158; dJ885L7.8应用: IHC反应种属: Human
-
分类: 科研抗体货号: P08255别名: MKP8; LDP-4; NATA1; SKRP3; DUSP24应用: IHC反应种属: Human, Mouse, Rat
-
分类: 科研抗体货号: P08235别名: DEP.8; SDP35; DEPDC1A; DEPDC1-V2应用: WB反应种属: Human
-
分类: 科研抗体货号: P08214别名: DARPP32; DARPP-32应用: IHC反应种属: Human, Rat
-
分类: 科研抗体货号: P08254别名: VHZ; MOSP; LDP-3; DUSP25; RP11-190A12.1应用: IHC反应种属: Human, Mouse
-
分类: 科研抗体货号: P08234别名: E3; LAD; DLDD; DLDH; GCSL; PHE3应用: IHC反应种属: Human, Mouse, Rat
-
分类: 科研抗体货号: P08213别名:应用: IHC反应种属: Human, Mouse

鄂公网安备42018502007531号
鄂公网安备42018502007531号

